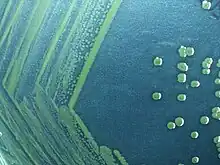

Shigella sonnei
Shigella sonnei est une bactérie responsable de shigellose, qui est une infection intestinale[1]. Cette bactérie est responsable de 90% des shigelloses[2]. Elle a été découverte par Carl Olaf Sonne[3]. 132 souches sont identifiées.
Structure
La bactérie est un bacille gram négatif immobile créant des flagelles. Elle est anaérobie facultative[4].
Maladie
Shigella sonnei est responsable de shigelloses. Cette shigellose se manifeste bénignement[5]. Les personnes à risques sont les nourrissons, les jeunes enfants, les personnes âgées, les immunodéficients, les voyageurs dans des pays à faible niveau d'hygiène, les personnes déjà atteintes par une maladie intestinale et les hommes homosexuels.
Symptômes
Au bout d'un moment, après avoir ingéré la bactérie, une diarrhée apparaît accompagnée de douleurs abdominales, de crampes, de vomissements possibles, d'une fièvre possible, de nausées et d'une dysenterie (les dysenteries causées par les shigelles sont appelées dysenteries bacillaires, pour l'autre type, voir dysenterie amibienne)[6]. Après, la plupart des personnes surtout immunocompétentes et adultes guérissent. Si la maladie persiste et le patient n'est pas pris en charge, des complications apparaissent[7].
Complications
Les complications possibles sont :
- la bactériémie, qui apparaît lorsque les bactéries passent dans le sang et s'y multiplient ;
- le syndrome hémolytique et urémique lorsque les bactéries entrent dans le système digestif dans lequel elles vont lyser les hématies[8] ;
- la déshydratation, lorsque la diarrhée entraîne des pertes d'eau dont l'organisme a besoin, donc les organes vont manquer d'eau, mal fonctionner et puis s'éteindre si la déshydratation n'est pas traitée. Les crises convulsives sont une des complications[9] ;
- l'arthrite réactionnelle, une inflammation des articulations, est également une complication possible ;
- le mégacôlon toxique, paralyse l'intestin ou cause un passage de gaz et enfin le prolapsus rectal[10].
Transmission
La transmission se fait par voie féco-orale. Les bactéries vont se multiplier dans les intestins afin de les coloniser. Ainsi, l'organisme va s'en débarrasser avec une diarrhée ou avec des vomissements associés à la diarrhée[11]. Les bactéries sont contenues dans les selles ou contenues aussi dans les vomissements du malade[3].
Prévention
La prévention repose sur l'hygiène en se lavant les mains avec du savon et laver les aliments avant de les manger.
Voir aussi
Articles connexes
- Dysenterie
- Shigellose
- Shigella
- Diarrhée
- Bactérie
- Infection
- Maladie intestinale
Références
- A. B. Makar, K. E. McMartin, M. Palese et T. R. Tephly, « Formate assay in body fluids: application in methanol poisoning », Biochemical Medicine, vol. 13, no 2, , p. 117–126 (ISSN 0006-2944, PMID 1, lire en ligne, consulté le )
- K. S. Bose et R. H. Sarma, « Delineation of the intimate details of the backbone conformation of pyridine nucleotide coenzymes in aqueous solution », Biochemical and Biophysical Research Communications, vol. 66, no 4, , p. 1173–1179 (ISSN 1090-2104, PMID 2, lire en ligne, consulté le )
- Y. W. Chow, R. Pietranico et A. Mukerji, « Studies of oxygen binding energy to hemoglobin molecule », Biochemical and Biophysical Research Communications, vol. 66, no 4, , p. 1424–1431 (ISSN 0006-291X, PMID 6, lire en ligne, consulté le )
- R. Roskoski, C. T. Lim et L. M. Roskoski, « Human brain and placental choline acetyltransferase: purification and properties », Biochemistry, vol. 14, no 23, , p. 5105–5110 (ISSN 0006-2960, PMID 40, lire en ligne, consulté le )
- R. D. Yoder, « Prearrest behavior of persons convicted of driving while intoxicated », Journal of Studies on Alcohol, vol. 36, no 11, , p. 1573–1577 (ISSN 0096-882X, PMID 555, lire en ligne, consulté le )
- K. Moroi et T. Sato, « Comparison between procaine and isocarboxazid metabolism in vitro by a liver microsomal amidase-esterase », Biochemical Pharmacology, vol. 24, no 16, , p. 1517–1521 (ISSN 1873-2968, PMID 8, lire en ligne, consulté le )
- A. Schmoldt, H. F. Benthe et G. Haberland, « Digitoxin metabolism by rat liver microsomes », Biochemical Pharmacology, vol. 24, no 17, , p. 1639–1641 (ISSN 1873-2968, PMID 10, PMCID PMC5922622, DOI 10.7861/clinmedicine.9-1-10, lire en ligne, consulté le )
- (en) K. A. Abraham et T. S. Eikhom, « Determination of polyadenylate-rich ribonucleic acid in the nucleus and in the cytoplasm of plasmacytoma cells », The Biochemical Journal, vol. 149, no 3, , p. 669–674 (ISSN 0264-6021, PMID 999, PMCID PMC1165673, lire en ligne, consulté le ).
- (en) D. L. Peterson, J. M. Gleisner et R. L. Blakley, « Bovine liver dihydrofolate reductase: purification and properties of the enzyme », Biochemistry, vol. 14, no 24, , p. 5261–5267 (ISSN 0006-2960, PMID 45, lire en ligne, consulté le ).
- (en) U. N. Wiesmann, S. DiDonato et N. N. Herschkowitz, « Effect of chloroquine on cultured fibroblasts: release of lysosomal hydrolases and inhibition of their uptake », Biochemical and Biophysical Research Communications, vol. 66, no 4, , p. 1338–1343 (ISSN 1090-2104, PMID 4, lire en ligne, consulté le ).
- O. Isaac et K. Thiemer, « [Biochemical studies on camomile components/III. In vitro studies about the antipeptic activity of (--)-alpha-bisabolol (author's transl)] », Arzneimittel-Forschung, vol. 25, no 9, , p. 1352–1354 (ISSN 0004-4172, PMID 21, lire en ligne, consulté le )
- Portail de la médecine